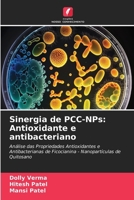
Sinergia de PCC-NPs: Antioxidante e antibacteriano 6207331214 Book Cover
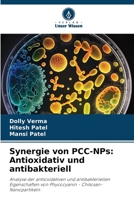
Synergie von PCC-NPs: Antioxidativ und antibakteriell 6207331168 Book Cover
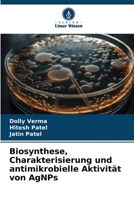
Biosynthese, Charakterisierung und antimikrobielle Aktivität von AgNPs 6207331109 Book Cover

- The Lens of Perfection
- Synthèse organique catalysée par KAl(SO4)2.12H2O (alun) (French Edition)
- Sintesi organica catalizzata da KAl(SO4)2.12H2O (allume) (Italian Edition)
- Síntese orgânica catalisada por KAl(SO4)2.12H2O (alum) (Portuguese Edition)
- KAl(SO4)2.12H2O (alun) katalizowana synteza organiczna (Polish Edition)